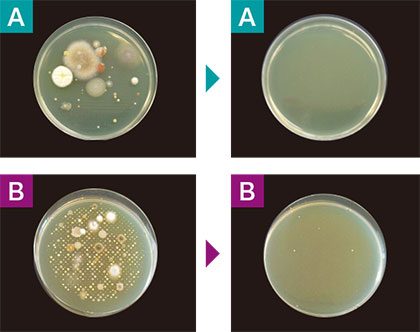

UVGI 紫外線殺菌装置 AERO SHIELDエアロシールド

紫外線照射で殺菌する新しい空気感染対策
あらゆる菌からあなたを守る
「AERO SHIELD」は高さ2.1m以上(安全基準)の天井面に紫外線の殺菌ゾーンを形成します。紫外線の中でも高い能力を持つ「UV-C」ランプを使用しており、インフルエンザ、ノロウイルスなどのウイルス、結核菌などの細菌類、黒かびなどの真菌類にいたるまて、すべての菌に対して有効です。
また紫外線が菌の核を直接死滅させるため、耐性菌が出てこないのも大きなメリット。
空調や人の出入りなど、屋内で起こる空気の自然滞留を利用して、空間全体の浮遊菌に一年を通して優れた効果を発揮します。

実空間の浮遊菌が減少
「AERO SHIELD」は第三者研究機関の実証試験により「実空間における浮遊菌減少が89.6%」と高い殺菌効果が認められています。
この試験は試験用ボックスではなく実際に人が生活する広さの空間て行われており、実用性も証明されています。また、医療機関をはじめ様々なお客様の施設においても実証試験を行い、高い効果を確認しております。
人体に安心な特殊ルーバー
高い効果と並ぶ「AERO SHIELD」のもう一つの大きな強みは“人がいる空間で安全に使える”点。
特殊なルーバー構造による紫外線の水平照射の実現で、人が生活する空間に影響を及ぼすことなく24時間安全に使用が可能です。
またエボラ対策などにあたった米国疾病対策センター(CDC)のガイドラインに準拠した製品として、その安全性と効果の高さから大学病院を始め、多数の施設で導入されています。
低コスト&長寿命!
コンパクト(W28cm×H12cm×D12.5cm)で約3kgと軽量なので、既存建物への導入も簡単。工期が短いので最小限の業務停止で設置できます。
長寿命高性能紫外線ランプを使用していますので、24時間連続使用しても電気代は1日7.1円※で済みます。
専用設計により反射板の交換が不要のため、約半年に一度ランプの交換をするだけで、日常の保守点検は必要ありません。※ 電気代の換算(型式UKP18:23円/Kwで算出)

